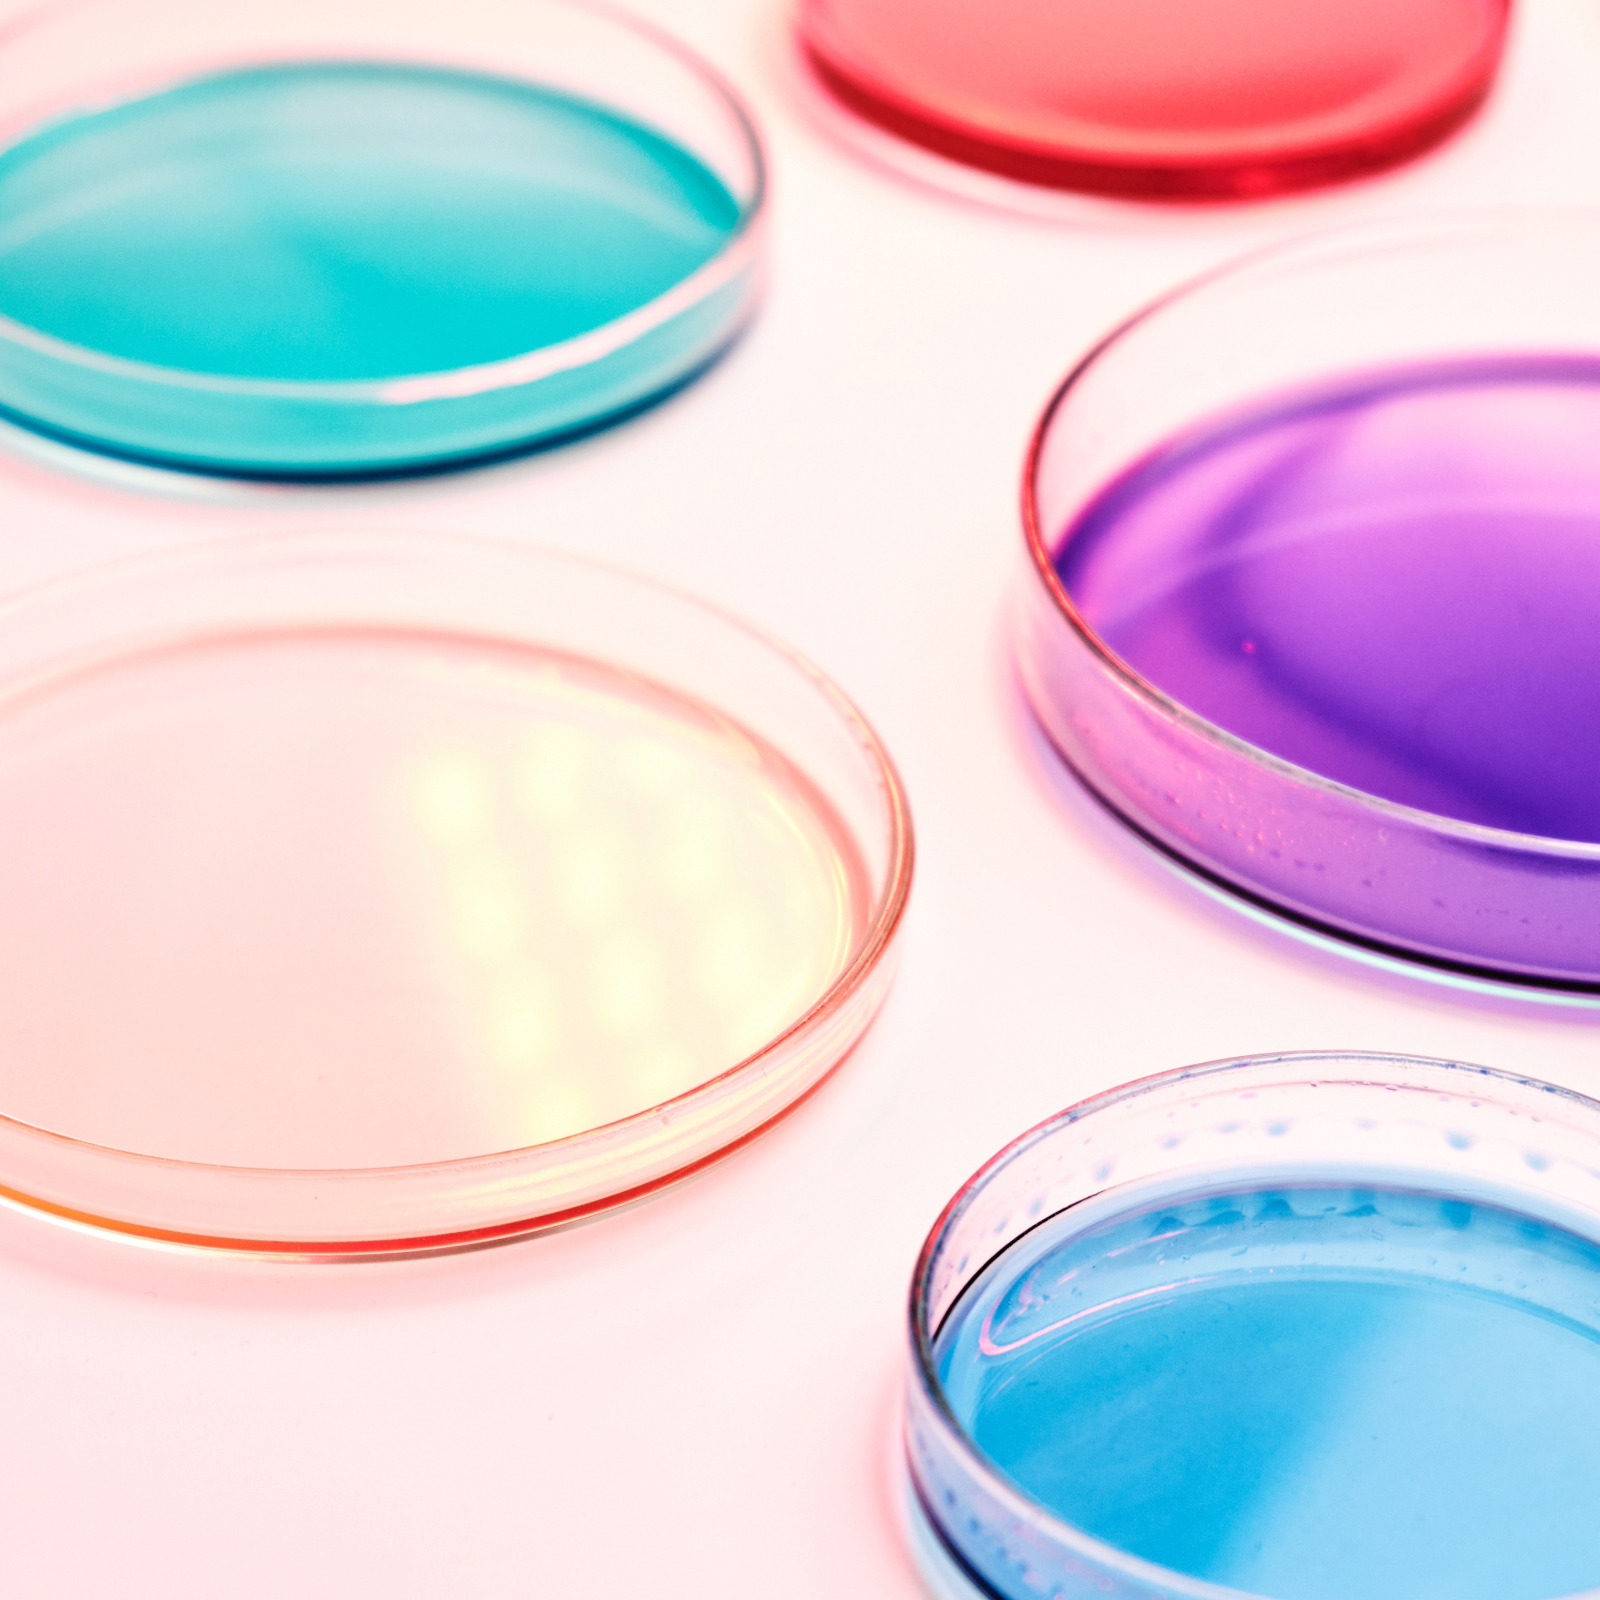
test glasses

Biomedical Scientist Recruitment Across the UK
Quad Recruitment is proud to support the people behind the science. From microbiology to haematology, we help biomedical professionals find roles that make a difference in hospitals, research facilities, and private labs. Whether you’re a newly qualified scientist or an experienced specialist, we’re here to help you take your next step.
Find your Role
Let's find you the perfect role
What is a Biomedical Scientist?
Biomedical science is at the heart of modern healthcare. It involves the investigation of samples such as blood, tissues and fluids to support diagnosis, monitor treatment, and advance research. Biomedical scientists play a critical role in detecting disease, developing medical knowledge, and supporting frontline clinical decisions.
Within the UK, biomedical scientists typically work in NHS or private pathology labs, universities, and research institutions. It’s a dynamic field that combines scientific expertise with clinical responsibility, making it an essential part of patient care.


Looking to Hire an Allied Health Professional?
Quad Recruitment partners with hospitals, clinics, community health services, and private healthcare providers to deliver highly qualified AHPs quickly and compliantly. Whether you need permanent staff, locums, or temporary cover, our sector-specific expertise and nationwide network make recruitment easy, reliable, and stress-free.
Why Choose Quad Recruitment for Bio-Medical Hiring?
Tailored Recruitment Solutions
We take the time to understand your organisation’s goals, values and team dynamic.
Find Qualified Biomedical Scientists
We connect you with pre-vetted, HCPC-registered professionals ready to contribute from day one.
Ongoing Support at Every Step
We stay by your side throughout your journey- before, during and after placement.
Fast and Reliable Hiring Support
From urgent cover to permanent placements, we respond quickly to your workforce needs.
Who We Partner With in Biomedical Science
At Quad Recruitment, we specialise in connecting employers with top biomedical talent across the UK. Our focus is on understanding both the technical skills and cultural fit required to succeed in this sector. Whether you’re a candidate looking for your next challenge or an organisation needing to fill a specialist vacancy, we offer tailored recruitment solutions to support you.
We partner with organisations and professionals in the following areas:
-
NHS laboratories and specialist testing units
-
Private healthcare providers and diagnostic centres
-
Universities and academic research institutions
-
Blood transfusion services and cellular pathology
-
Contract research organisations (CROs) and biotech labs
-
Both long-term permanent and short-term contract roles
What Roles Do We Support in Biomedical Science?
Laboratory and Testing Roles
-
Biomedical Scientist – Haematology
-
Biomedical Scientist – Microbiology
-
Biomedical Scientist – Clinical Biochemistry
-
Biomedical Scientist – Immunology
Specialist and Advanced Roles
-
Specialist Biomedical Scientist
-
Senior Biomedical Scientist
-
Lead Biomedical Scientist
Academic and Research Roles
-
Research Biomedical Scientist
-
Lab-based Research Assistant
-
Clinical Trials Laboratory Technician
Locum and Interim Roles
-
Locum Biomedical Scientist
-
Shift-based BMS Technicians
-
Short-term Lab Contract Roles
Don’t see the role you’re looking for? Not to worry!
We recruit across the full Biomedical Science spectrum!

Frequently Asked Questions- Biomedical Science
Can I work as a locum biomedical scientist?
Yes. Locum opportunities are widely available in NHS hospitals, private laboratories, and research facilities. Locum roles offer flexibility, higher daily rates, and experience across different laboratory settings.
Do you support international biomedical scientists?
Yes. International candidates who meet HCPC registration requirements and visa eligibility can apply. Quad Recruitment assists overseas professionals in securing roles and navigating the UK regulatory process.
Why use an agency like Quad Recruitment to hire biomedical scientists?
Employers gain access to pre-screened, highly skilled candidates, saving time and reducing the risk of a bad hire. Our sector expertise, nationwide network, and compliance management ensure fast, reliable recruitment for permanent or locum positions.
What does a biomedical scientist do?
Biomedical scientists work in laboratories to analyse samples, support diagnosis, and assist patient treatment. They specialise in areas such as haematology, microbiology, biochemistry, transfusion science, and pathology.
How much do biomedical scientists earn in the UK?
Salaries depend on experience and sector. Newly qualified biomedical scientists typically start on NHS Band 5, while senior or specialist roles progress to Band 6 or 7. Locum positions can offer competitive day rates.
What types of organisations employ biomedical scientists?
Biomedical scientists work in NHS pathology labs, private laboratories, research facilities, universities, and specialist diagnostic centres. Employers benefit from candidates who are fully qualified, compliance-checked, and ready to contribute immediately.
How do I register with Quad Recruitment as a biomedical scientist?
Submit your CV online or speak directly with our specialist biomedical science recruitment team to explore current vacancies and upcoming opportunities. Call us HERE
What qualifications do I need to work as a biomedical scientist in the UK?
You need a recognised biomedical science degree and registration with the Health and Care Professions Council (HCPC). Some specialist roles may require postgraduate qualifications or additional laboratory experience.
Looking to Hire or Get Hired in Biomedical Science?
Whether you’re scaling your biomedical business or searching for your next role in science, we’re ready to support you with market insight, top-tier talent, and fast, effective results.
